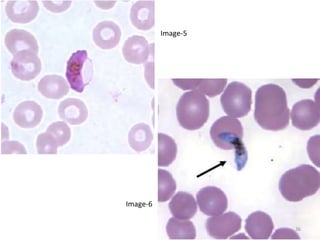
36
Image-5
Image-6
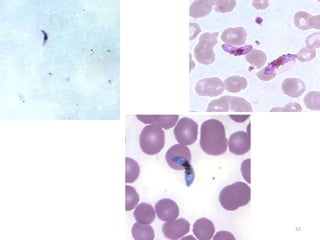
53
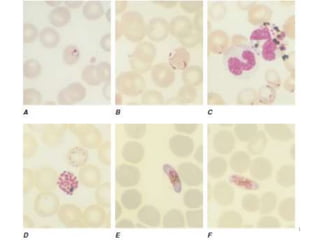
151
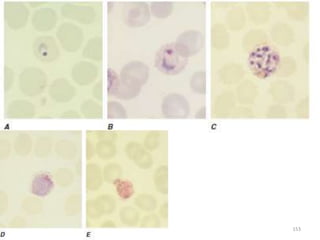
153

The document provides a detailed overview of malarial parasites, focusing on the genus Plasmodium, particularly P. falciparum. It includes descriptions of the life cycle, gametocytogenesis, clinical symptoms, pathogenesis, and the historical timeline of malaria research and treatment. The document emphasizes the pathogenicity of P. falciparum, its virulence mechanisms, and the pathological changes it induces in various organs.













![Plasmodium falciparum-LIFE CYCLE
Human cycle begins with a bite of Infected
Female Anopheles mosquito/ Transfusion of
Infected blood
(Except-> Transfusion malaria and Congenital
malaria)
There are 2 stages in the Human cycle
1] Exo-erythrocytic (EE) schizogony in the Liver
2] Erythrocytic schizogony in the RBCs.
14](https://image.slidesharecdn.com/malaria-210531105144/85/Malaria-14-320.jpg)

![Pathological changes in various organs
Histopathology of the lung in a fatal case of adult
falciparum malaria
There is expansion of alveolar capillaries by
sequestered parasitized erythrocytes and host
inflammatory leukocytes.
Monocytes and neutrophils within alveolar septal
capillaries contain phagocytosed hemozoin
pigment
(hematoxylin and eosin [H&E] staining,
magnification 3 400,
84](https://image.slidesharecdn.com/malaria-210531105144/85/Malaria-84-320.jpg)
![Pathological changes in various organs
HEAMATOLOGICAL CHANGES
Anemia-
1] Enormous destruction of both Parasitised and non-
parasitised RBCs- Antigenically different Parasitised
RBCs bind with the non-parasitised and form Rossets and
block vanules.
Non parasitised RBCs are destroyed probably by auto-
immune mechanism.
2] Decreased erythropoesis in Bone marrow- This is in
part due to TNF Toxicity. In long term infection there may
be Leucopenia & decreased Hb levels
85](https://image.slidesharecdn.com/malaria-210531105144/85/Malaria-85-320.jpg)




![Clinical manifestations
The clinical symptoms can be divided into –
A] Prodromal period
B] Malarial paroxysm
C] Anemia
D] Hepatospleenomegaly.
Prodromal period- Malarial paroxysm is preceded by a Prodromal
period which varies from a few to several days.
Non-specific symptoms such as
Malaise,
Myalgia,
Headache, and Fatigue are seen.
Local symptoms like Chest pain, Abdominal pain and Arthralgia
are also found.
90](https://image.slidesharecdn.com/malaria-210531105144/85/Malaria-90-320.jpg)









































![Recurrence of Clinical malaria
Recurrence of clinical malaria after treatment may occur
due to 3 reasons-
1] True relapse: It is caused by Hypnozoites in P. vivax & P.
ovale.
It is due to re-emrgence of blood stage parasites from latent
parasites(Hypnozoites) in liver.
Since no Hypnozoites in P. falciparum No true relapse.
2] Recrudescence- It is seen falciparum malaria d/t
inadequate t/t and seen in – Drug resistance, Immuno-
suppression & pregnancy.
132](https://image.slidesharecdn.com/malaria-210531105144/85/Malaria-132-320.jpg)
![Recurrence of Clinical malaria
3] Latent malaria- This condition refers to a
state of asymptomatic malaria harbouring
plasmodia gametocytes in the peripheral blood.
These persons are infectious to mosquitoes and
act as Reservoirs .
133](https://image.slidesharecdn.com/malaria-210531105144/85/Malaria-133-320.jpg)